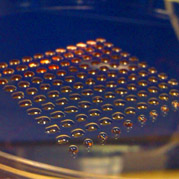

Las primeras impresoras 3D se crearon en los ochentas. Sin embargo, su auge se ha dado en los últimos años gracias a nuevas necesidades del consumidor. Los dispositivos se utilizan para la experimentación y el avance científico, pero su gran demanda nace por los beneficios que puede para el hogar. La impresión 3D será clave para el crecimiento de los hogares inteligentes.
L os primeros modelos de impresoras 3D tenían una función enfocada a la maquinaria. Se siguen utilizando para moldear metales derritiéndolos para crear estructuras sin moldes. La cantidad de energía y los riesgos de manejo tienen estas potentes maquinas lejos de los usuarios. Por suerte, las fibras de termoplástico solucionaron los riesgos de manipulación, son mucho más baratos que una lamina de metal y las máquinas pueden ser más pequeñas y accesibles para el consumidor.
El termoplástico tiene la ventaja de ser moldeable a temperaturas bajas; algunos se pueden moldear incluso con un secador de pelo. Esto permitió el nacimiento de impresoras 3D como ‘Cubify’, la cual deja imprimir objetos pequeños con facilidad. Gracias a estas impresoras nacieron nuevos mercados que venden platos plásticos, jarrones, utilería para el escritorio, pequeñas decoraciones y fotografías personales como muñequitos coleccionables.
Impresión exitosade células madre.
Impresión exitosade células madre.
El nacimiento de estos mercados impulsó a nuevos ingenieros a explotar más el recurso de los termoplásticos y las impresoras. Actualmente hay algunas máquinas caseras de gran escala que utilizan los termoplásticos para estructuras más grandes. ‘BigRep’ es una de ellas, convirtiéndose en la primera impresora casera para imprimir muebles. También está la iniciativa de proyectos como ‘The 3D Print Canal House’ que busca construir una casa de 13 habitaciones con sólo estructuras construidas en plásticos, ya que podría disminuir el valor de los materiales, construcción y tiempos de transporte. La cantidad de energía y los riesgos de manejo tienen estas potentes maquinas lejos de los usuarios.
Paralelamente, la ciencia no se quedó atrás. Los científicos y diseñadores comenzaron a experimentar con la impresión 3D haciendo férulas y reemplazando estructuras del cuerpo; luego utilizando materiales orgánicos para recrear comida e incluso células madre. Experimentos que por su éxito están impulsando la creación de impresoras de material orgánico como ‘Foodini’, una impresora 3D que lo ayudará a preparar sus platillos favoritos. Muchas de ellas son impulsadas por sitios de crowdfunding como Kickstarter e Indiegogo.
No pasaran muchos años antes de ver que en todas las casas hay una impresora 3D. Algunas personas gustan de renovar sus decoraciones, encuentran modelos exóticos y diseñan sus propios objetos. Los hogares del futuro llevaran a muchas personas a estar en contacto con su lado creativo para sacar el mayor provecho a estas nuevas tecnologías.
Artículo de Julián Gabriel Pietra Fuente: Techniq.com